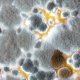
The dangers of mould in the home

Keeping Your Artificial Grass Pristine: Essential Maintenance Tips

Artificial grass is a fantastic low-maintenance option for homeowners, but it still requires some care to keep it looking its best. Here are some essential maintenance tips to ensure your turf remains lush and vibrant:
1. Routine Cleaning and Maintenance
Regular cleaning is crucial for keeping artificial grass in optimal condition. This includes removing debris, brushing, and surface grooming. Turfglo, a leading artificial grass cleaning company in Australia, offers comprehensive cleaning services to help maintain the pristine appearance of your turf.
2. Odor Elimination
Over time, odors from pet urine, bacteria, mold, and other sources can accumulate. Specialized treatments from Turfglo can effectively eliminate these unpleasant smells, ensuring your outdoor space remains fresh and inviting.
3. Deep Cleaning
Embedded dirt, dust, allergens, and debris can dull the appearance of your turf. Turfglo provides deep cleaning services that reach the base of the fibers, restoring the fresh and clean look of your artificial grass.
4. Pet Waste Management
Pet waste can create unsanitary conditions and unpleasant odors. Turfglo’s sanitization and deodorization services target areas affected by pet waste, maintaining a hygienic and odor-free environment for your family and pets.
5. Infill Replacement
To maintain proper drainage, resilience, and performance, periodic replacement of infill material is necessary. Turfglo can assess and replace infill to ensure your artificial turf system functions optimally.
6. Repairs and Restoration
Over time, wear and tear can lead to damage. Turfglo offers repair and restoration services, including seam repairs and overall turf rejuvenation, extending the lifespan of your artificial grass.
7. Surface Disinfection
Regular disinfection is important to reduce the risk of bacterial and viral contamination. Turfglo applies effective disinfectants to sanitize the artificial turf surface, promoting a safer environment for everyone.
8. Consultation and Advice
Proper maintenance can significantly extend the life of your artificial grass. Turfglo provides expert advice and consultation on best practices and product recommendations to help you care for your turf.
Why It’s Important to Hire Professional Artificial Grass Experts Like Turfglo
Expertise and Experience
Turfglo’s professional team has extensive experience and expertise in artificial grass cleaning. Their deep understanding of different turf materials and the best cleaning techniques ensures that your grass remains in top condition without risk of damage.
Kid-Safe Solutions, Pet-Safe and Eco-Friendly
Unlike many other cleaning services, Turfglo is dedicated to using eco-friendly, biodegradable cleaning products that are safe for both the environment and your family, including your furry friends. This is particularly important if you have children and pets who play on the grass, as it eliminates exposure to harmful chemicals. Many cleaning companies do not prioritize safety and environmental sustainability, making Turfglo a standout choice for maintaining a pet-safe and eco-friendly artificial grass landscape.
Affordable Rates
Professional cleaning services might seem like a luxury, but Turfglo offers competitive and affordable rates. Investing in professional cleaning can save you money in the long run by extending the life of your artificial grass and preventing costly repairs.
Thorough Cleaning and Maintenance
Professionals like Turfglo have access to advanced equipment and cleaning solutions that ensure a deeper and more thorough clean than what most homeowners can achieve on their own. This includes specialized treatments for odor elimination, deep cleaning, and effective sanitization.
Peace of Mind
Hiring Turfglo gives you peace of mind, knowing that your artificial grass is being cared for by experts. They handle all aspects of maintenance, from routine cleaning to repairs, allowing you to enjoy a pristine outdoor space without the hassle and risk of DIY cleaning.
By partnering with Turfglo, you can ensure your artificial grass remains beautiful and functional, providing a perfect outdoor space for years to come.
Frequently Asked Questions
1. How often should I clean my artificial grass to reduce allergens?
Regular cleaning of artificial grass is essential to maintain its appearance and longevity. TurfGlo offers cleaning service packages for your needs, from 1 time, 4 per year, and monthly deep cleaning. Regular cleaning is definitely recommended to keep your artificial grass in optimal condition. Read More
2. What are the common mistakes to avoid in artificial grass maintenance?
Avoid using harsh chemicals, overwatering, neglecting regular brushing, and allowing debris to accumulate on your artificial grass. These common mistakes can damage the turf and impact its overall performance. Read More
3. Allergens on Artificial Grass Dangerous?
Allergens on artificial grass can pose health risks, particularly for individuals with allergies or respiratory issues. Pollen, dust, and other airborne particles can accumulate on the surface, triggering allergic reactions such as sneezing, itching, and watery eyes. Additionally, mold and mildew growth on the turf can exacerbate symptoms and lead to respiratory problems. Read More
4. Is it necessary to hire professional cleaning services for maintaining an allergen-free artificial grass, or can I effectively clean it myself?
Professional cleaning services, like those from Turfglo, are essential for thoroughly removing allergens, ensuring your artificial grass remains a safe environment. DIY methods often fall short. Read More

Leave a Reply
Want to join the discussion?Feel free to contribute!